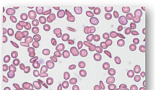
GBT, 사노피 'SCD 치료 저분자약물’ 3.5억弗 사들여

검색
검색어를 입력하세요.
-
GBT, 사노피 'SCD 치료 저분자약물’ 3.5억弗 사들여
윤소영 기자 2021-03-19 06:44
-
피씨엘, 405억 규모 CB발행∙유상증자 결의
서윤석 기자 2021-03-18 17:46
-
대웅제약, 자사주 2.6% 처분..."400억 R&D 투자"
김성민 기자 2021-03-18 17:37
-
한미약품 "첫 바이오신약" '롤론티스' 식약처 허가
김성민 기자 2021-03-18 16:57
-
쓰리빌리언, 시리즈C 140억..”희귀질환 AI진단 고도화”
서윤석 기자 2021-03-18 16:42
-
헬릭스미스, 김선영 대표 경영서 물러난다
김성민 기자 2021-03-18 15:19
-
머크, 아마투스와 뇌질환 '미토콘드리아 표적' "옵션딜"
김성민 기자 2021-03-18 13:22
-
JW중외제약, 통풍신약 국내 2b상 “요산감소 긍정적”
서윤석 기자 2021-03-18 11:32
-
엠디뮨-EVERCYTE, 항암 '약물전달 시스템' 공동연구
노신영 기자 2021-03-18 11:19
-
신한생명-루닛, 디지털헬스 MOU.."건강검진 AI 진단"
김성민 기자 2021-03-18 10:47
-
대웅제약, ‘펙수프라잔’ 3845억 "中 13년 공급계약”
서윤석 기자 2021-03-18 10:02
-
릴리, 'IL-23 항체’ UC 3상 '긍정적'..“경쟁약에 한발 앞서”
서윤석 기자 2021-03-18 09:50
-
딥바이오, USCAP서 ‘AI 암진단’ 연구결과 4건 발표
서윤석 기자 2021-03-18 09:29
-
고바이오랩, 면역 마이크로바이옴 1상 "안전성 등 확인"
김성민 기자 2021-03-18 08:38
-
GSK-獨머크, 'TGF-βxPD-L1' 또 실패.."그래도 계속"
김성민 기자 2021-03-18 07:03